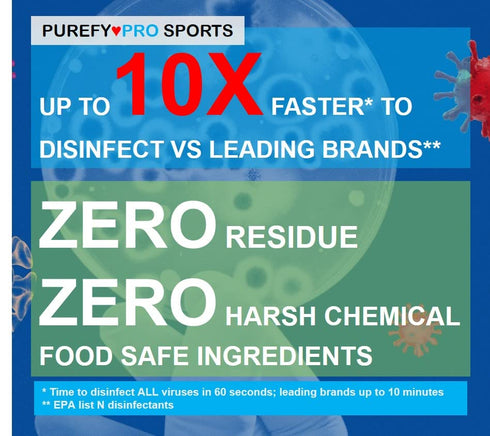
Purefypro Sports Equipment Disinfectant Spray - (3.4oz, 2pk) TSA Travel Size. Kills 99.9999% MRSA, HIV, Athlete Foot Fungus, Virus and Fungi. No R...

Purefypro Sports Equipment Disinfectant Spray - (3.4oz, 2pk) TSA Travel Size. Kills 99.9999% MRSA, HIV, Athlete Foot Fungus, Virus and Fungi. No Rinse, No Residue. Great For Sports Pads, Yoga Mats,
HEALTHIER: Kills drug resistant MRSA, VRE and fungus, Kills Norovirus, HIV (Aids virus) and Influenza, Norovirus, Hepatitis in as short as 60 seconds. Prevents growth of damaging mold and mildew. Eliminates odors and allergens.
PURER: Free of alcohol, synthetic fragrance, and VOC; No harsh chemical residue (turns into water)
SAFER: Noncorrosive, pH balanced; Safe for sensitive materials like rubber gym mat use; Recommended by doctors for sensitive population including allergic asthma, atopic dermatitis (eczema), immunodeficient etc.
PROVEN: Proven by hospitals, senior care, and childcare facilities to protect those most vulnerable from germs, allergens, and contaminants.
- FREE standard shipping within the United States(3-6 Days)on all orders!
- 100% money back guarantee for items not delivered or damaged during shipping.
- Safe and secure checkout with our high quality encryption
- Shipping services: UPS, FedEx, USPS.
- Only ship to the lower 48 states, no APO/FPO addresses or PO Boxes allowed.
- Local pickups and combined shipping options are not provided at this time.
- You can return a product for up to 30 days from the date you purchased it.
- Any product you return must be in the same condition you received it and in the original packaging. Please keep the receipt.
- A full refund if you don’t receive your order A full refund if your order does not arrive within the guaranteed time (6-7 business days not including 1 processing day.)
We accept payment by any of the following methods:
Credit Cards, PayPal, Shop Pay, Apple Pay, Google Pay, Amazon Pay, Meta Pay
Customer satisfaction is very important to us.
If you have any problem with your order, please contact us and we will do our best to make you satisfied.
If you have any queries, please contact us via
Support@ZeeBooth.com
We usually respond within 24 hours on weekdays.